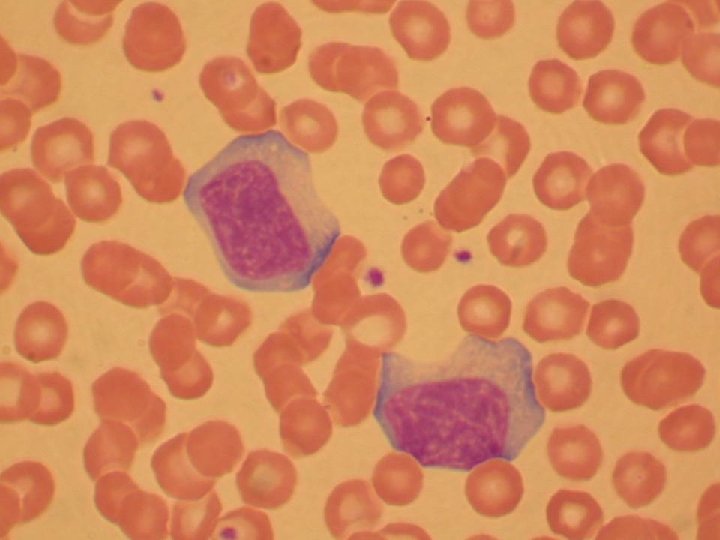
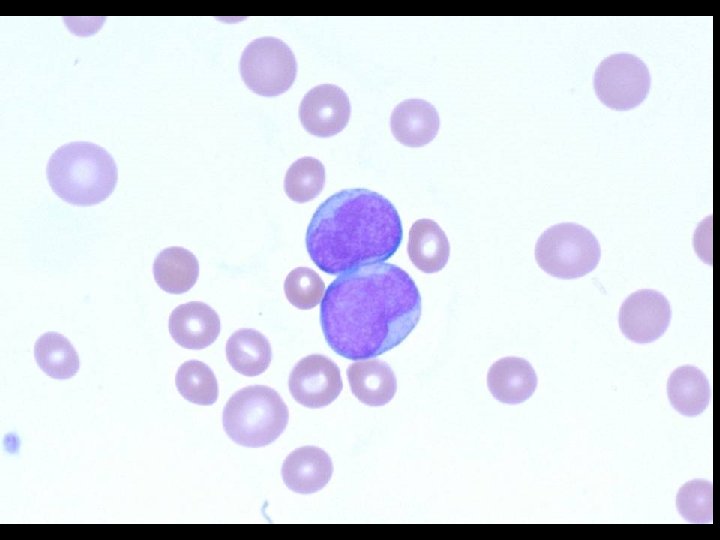
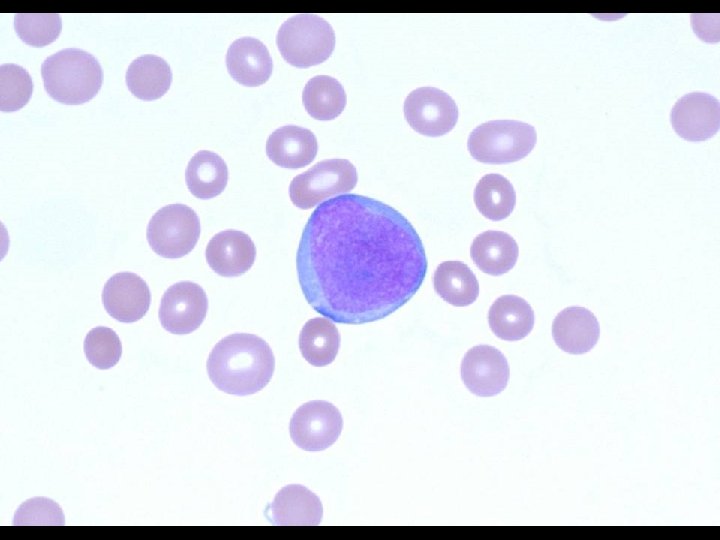

THE DEVELOPMENT OF BLYMPHOCYTES STAGES IN LIFE CYCLE

THE DEVELOPMENT OF B-LYMPHOCYTES

STAGES IN LIFE CYCLE OF B-LYMPHOCYTES * Stage 1 * Maturation in bone marrow with development of functional receptors * Stage 2 * Testing for and elimination of self-reactive receptors * Stage 3 * Mature naïve cells move to secondary lymphoid tissues * Stage 4 * Antigen contact with differentiation into plasma cells and memory cells




B-CELL DEVELOPMENT IN BONE MARROW * Stages are defined by rearrangement and expression of IG genes * Early Pro-B cells * Earliest cells in B-cell lineage * Rearrangement of variable domain of heavy chains * D to J * Late Pro-B cell * Rearrangement of variable domain of heavy chains * V to DJ

B-CELL DEVELOPMENT IN BONE MARROW * Large Pre-B cell * M expressed on cell surface along with surrogate light chains and signal transduction molecules * Pre-B cell receptor * Small Pre-B cell * Pre-B cell receptor not present * Most M chains inside cell * Light chain rearrangement begins

B-CELL DEVELOPMENT IN BONE MARROW * Immature B-cell * Heavy and light chains assembled and transported to surface as Ig. M receptor complex * Randomness of gene rearrangements leads to selfreactive B-cells * Mature B-cell * Ig. D expressed on cell surface * Called naïve B-cells


Figure 4 -4

B-CELL DEVELOPMENT IN BONE MARROW * Development depends on non-lymphoid stromal cells * Function of stromal cells * Specific contact through cell adhesion molecules (CAM’s) * VCAM-1 to VLA-4 on early pro-B cells * Produce growth factors for bound B-cells * Stem cell factor (SCF) * Interleukin-7 (IL-7) * Growth factors * Stem cell factor stimulates (G/P) of Early pro-B cells * Interleukin-7 stimulates (G/P) of Late pro-B and L/S pre-B cells


GENE REARRANGEMENTS AND BCELL SURVIVAL * Gene rearrangement process is imprecise and classified as * Unproductive * Not translated into IG chain * B-cell dies * Productive * Translated into IG chain * Development proceeds * Immunoglobulin loci * Each B-cell has 2 copies on homologous chromosomes * Rearrangements made on both



PROTEINS INVOLVED IN REARRANGEMENT AND EXPRESSION OF IG GENES * Several categories of specialized proteins are required * Lymphoid specific recombination * RAG-1 and RAG-2 * N-nucleotide addition * Td. T * Surrogate light chains * Lambda 5 and Vpre. B * Signal transduction * IG-alpha, IG-beta, CD 45 and Btk * Transcription factors * EBF and Oct-2



SIGNAL TRANSDUCTION AND BRUTON’S TYROSINE KINASE (BTK) * Bruton’s tyrosine kinase (Btk) * Encoded by gene on X chromosome * Essential for B cell maturation * Mutation in gene * B cells maturation stops at pre-B cell stage * Results in immunodeficiency called * Bruton’s X-linked agammaglobulinemia * Immunodeficiency results in recurrent sinopulmonary infections with * Streptococcus pneumoniae * Haemophilus influenzae

POPULATIONS (SUBSETS) OF B CELLS * B-1 cells (minor subset) * * * Develop early in embryonic life with unknown origin Express CD 5 (CD 5 B cells) Self-renewing Primary location is body cavities (pleural / peritoneal) Produce polyspecific antibodies * B-2 cells (major subset) * * * Develop after birth Do not express CD 5 glycoprotein Replaced from bone marrow Primary location is lymphoid organs Produce highly specific antibodies


NEGATIVE SELECTION AND FURTHER DEVELOPMENT OF B CELLS * Self reactive immature B cells are either * Eliminated or inactivated * Ig. M receptor may react with * Cell surface or soluble self antigens * Reactions with cell surface antigens * Induced to commit suicide by apotosis * Clonal deletion * Reactions with soluble antigens * Rendered unresponsive (anergic) to antigen * Maturation continues with reduced surface Ig. M


SELECTION AND FURTHER DEVELOPMENT OF B CELLS * B cells leave bone marrow and circulate between blood and secondary lymphoid tissues * Secondary lymphoid tissue contains primary lymphoid follicles * Primary lymphoid follicle * Area where B cells congregate in association with specialized stromal cells (follicular dendritic cells) * Passage through primary lymphoid follicle and contact with follicular dendritic cells (FDC) necessary for survival * Few days with no passage * 3 to 8 weeks with passage

CIRCULATION OF B CELLS THROUGH SECONDARY LYMPHOID TISSUES (LYMPH NODES) * Chemokines attract B cells to leave blood and enter cortex of lymph node via high endothelial venule (HEV) * Chemokines attract B cells to lymph node and primary lymphoid follicle * No encounter with antigen * B cells leave node via efferent lymphatic vessel * Anergic B cells detained in T cell area * Induced to commit suicide by apoptosis



B CELL ENCOUNTER WITH ANTIGEN IN SECONDARY LYMPHOID TISSUES * Encounter with antigen takes place in T cell area of lymph node cortex * Antigen reached lymph node from infected tissue via afferent lymphatic vessel * B cell is activated by CD 4 T-cell in T-cell area * Activated B cells * Migrate to medulla area and differentiate into plasma cells * Migrate to primary follicle to form germinal center * Migrate to medulla or bone marrow and complete differentiation into plasma cells * Develop into memory B cells


B-LYMPHOCYTE TUMORS * Caused by mutations in genes that regulate cell growth * Genes regulating cell growth * Proto-oncogenes * Promotes cell growth * Tumor suppressor genes * Inhibits cells growth * Mutations in growth regulating genes * Transformation into oncogenes (cancer causing genes)

B LYMPHOCYTE TUMORS * Represents uncontrolled growth of single transformed B cell * Associated with all stages of development * Tumors retain characteristics of cell type and location * Hodgkin’s Lymphoma * Germinal center B cell in lymphoid tissue * Multiple myeloma * Plasma cell in bone marrow * Waldenstrom’s macroglobulinemia * Ig. M secreting B lymphocyte in lymphoid tissue * Burkitt’s lymphoma * Resembles germinal center B cell in lymphoid tissue

Figure 4 -19

HODGKIN’S DISEASE (LYMPHOMA) * Hodgkin’s disease is a type of lymphoma * Two types of lymphoma * Hodgkin’s disease * Non-Hodgkin’s lymphoma (NHL) * Two main types of Hodgkin’s disease * Classical (95%) * Nodular lymphocyte predominance (5%) * Disease most often starts in lymph nodes of upper body * Chest, neck or under the arms

HODGKIN’S DISEASE (LYMPHOMA) * Cause is not known but there are risk factors * Epstein-Barr Virus (EBV) infection * Geography * United States, Canada, northern Europe * Family history * Identical twin (very high) * Approximately 8, 000 new cases each year in US * Cancer cells of HD are unique * Reed-Sternberg cells


WALDENSTROM’S MACROGLOBULINEMIA * Indolent, non-Hodgkin’s lymphoma (NHL) * Classified as * Monoclonal gammopathy * Cancer cells * Features of B-cells and plasma cells * Lymphoplasmacytoid * Located primarily in bone marrow * Produce large amounts of monoclonal protein (antibody) * Ig. M * Approximately 1, 500 new cases each year in US

MULTIPLE MYELOMA * Aggressive, non-Hodgkin lymphoma * Classified as * Monoclonal gammopathy * Cancer cells * Abnormal plasma cells (myeloma cells) * Located primarily in bone marrow * Produce monoclonal proteins (antibody) * Ig. G, Ig. A, free kappa or lambda light chains * Approximately 20, 000 cases in US for 2008

BURKITT’S LYMPHOMA * B cell tumor with 2 forms * Endemic (African) * Facial tumors * Strongly associated with EBV infection * Nonendemic (Sporadic) * Abdominal tumors * Characteristic translocation * MYC proto-oncogene on chromosome 8 to IG genes * Chromosome 14 (90%) * Chromosomes 2 and 22 (10%) * MYC protein * Normally regulates cell division * Control is lost following translocation to IG gene




CASE STUDY – 21 YEAR OLD MALE * 21 year old WM presents with * * Fever (102 F) Sore throat Moderate malaise, myalgia and fatigue Difficulty in swallowing * H and P * * Healthy and sexually active Bilateral anterior and posterior cervical lymphadenopathy Pharyngeal inflammation Mild splenomegaly and no jaundice

CASE STUDY – 21 YEAR OLD MALE * Admitted to MC and administered * Penicillin G * Prednisone * Valacyclovir * Laboratory tests * * * CBC with diff Liver function tests Monospot test (Heterophile antibody) Erythrocyte sedimentation rate (ESR) Group A streptococcus antigen

CASE STUDY – 21 YEAR OLD MALE * CBC with diff * * * WBC RBC Platelets Hemoglobin Hematocrit * * Neutrophils Lymphocytes Atypical lymphocytes Monocytes 12. 5 4. 0 250 14. 0 40 [4. 8 -10. 8] [3. 93 -5. 22] [150 -450] [11. 2 -15. 7] [34. 1 -44. 9] K/u. L M/u. L K/u. L g/d. L % 45 55 18 12 [40 -74] [15 -47] % % [0 -12]

REACTIVE (ATYPICAL) LYMPHOCYTES * Larger in size * Up to 30 um in diameter * * * More cytoplasm Less dense nuclear chromatin Irregular shaped nucleus Nucleous may be present Periphery of cell show “scalloped edge”

CASE STUDY – 21 YEAR OLD MALE * Liver function tests * ALT * AST * Alk phos * ESR 130 112 150 40 [19 -55] U/L [15 -37] U/L [50 -136] U/L [0 -30] mm/hr * GAS antigen Negative [Negative] * Monospot test Positive [Negative]



CASE STUDY – 21 YEAR OLD MALE * Patient discharged after 36 hours * Treatment * NSAID * Recommendations * Avoid sports * Avoid alcohol

CASE STUDY – 18 YEAR OLD FEMALE * 18 year old HF presents with * * Fever (101 F) Sore throat Moderate malaise, myalgia and fatigue Difficulty in swallowing * H and P * * Healthy and sexually active Bilateral anterior and posterior cervical lymphadenopathy Pharyngeal inflammation Mild splenomegaly and no jaundice

CASE STUDY – 18 YEAR OLD FEMALE * Admitted to MC and administered * Penicillin G * Prednisone * Valacyclovir * Laboratory tests * * * CBC with diff Liver function tests Monospot test (Heterophile antibody) Erythrocyte sedimentation rate (ESR) Group A streptococcus antigen

CASE STUDY – 18 YEAR OLD FEMALE * CBC with diff * * * WBC RBC Platelets Hemoglobin Hematocrit * * Neutrophils Lymphocytes Atypical lymphocytes Monocytes 13. 5 4. 2 260 14. 5 42 [4. 8 -10. 8] [3. 93 -5. 22] [150 -450] [11. 2 -15. 7] [34. 1 -44. 9] K/u. L M/u. L K/u. L g/d. L % 46 56 20 12 [40 -74] [15 -47] % % [0 -12]

CASE STUDY – 18 YEAR OLD FEMALE * Liver function tests * ALT * AST * Alk phos * ESR 136 115 156 42 [19 -55] U/L [15 -37] U/L [50 -136] U/L [0 -30] mm/hr * GAS antigen Negative [Negative] * Monospot test Negative [Negative]


CASE STUDY – 18 YEAR OLD FEMALE * Epstein-Barr Virus serology (IFA) * * * Viral capsid antigen (VCA) Ig. M Viral capsid antigen (VCA) Ig. G Early antigen (D + R) Ig. G Nuclear antigen (NA) Ig. M Nuclear antigen (NA) Ig. G 1: 320 1: 40 1: 20 1: 80 < 1: 10 [< 1: 20] [< 1: 10]


CASE STUDY – 18 YEAR OLD FEMALE * Patient discharged after 24 hours * Treatment * NSAID * Recommendations * Avoid sports * Avoid alcohol



CASE STUDY – 24 YEAR OLD FEMALE * 24 year old WF presents with * * Fever (101 F) Moderate malaise and fatigue Myalgia and bone pain Shortness of breath * H and P * * No significant history Generalized lymphadenopathy Pallor Mild splenomegaly and no jaundice

CASE STUDY – 24 YEAR OLD FEMALE * Admitted to MC with diagnosis of * Pneumonia and anemia * Laboratory tests * * CBC with diff Monospot test (Heterophile antibody) Pregnancy test Influenza A and B antigens

CASE STUDY – 24 YEAR OLD FEMALE * CBC with diff * * * WBC RBC Platelets Hemoglobin Hematocrit * * * Neutrophils Lymphocytes Atypical lymphocytes Monocytes Blasts 44. 4 1. 0 8 3. 6 11. 3 6 10 0 20 55 [4. 8 -10. 8] K/u. L [3. 93 -5. 22] M/u. L [150 -450] K/u. L [11. 2 -15. 7] g/d. L [34. 1 -44. 9] % [40 -74] [15 -47] [0 -12] % % %

![CASE STUDY – 24 YEAR OLD FEMALE * Pregnancy test Negative [Negative] * Influenza CASE STUDY – 24 YEAR OLD FEMALE * Pregnancy test Negative [Negative] * Influenza](http://slidetodoc.com/presentation_image_h/120f17c57996e7a7f82a19fec9317bb4/image-67.jpg)
CASE STUDY – 24 YEAR OLD FEMALE * Pregnancy test Negative [Negative] * Influenza antigens Negative [Negative] * Monospot test Positive [Negative] * Peripheral blood smear * RBCs showing anisopoikocytosis. Leukocytes show predominance of blasts many with cytoplasmic granules. Mature granulocytes show dysplastic features. Monocytes are atypical.

CASE STUDY – 20 YEAR OLD FEMALE * 20 year old WF presents to ED c/o * Chest pain * POCT * Troponin * CK MB * CK, Total 23. 21 44. 8 611 [< 0. 7] [< 3. 6] [21 – 215] ng/m. L U/L * Admitted to MC with diagnosis of * STEMI (ST segment elevation myocardial infarction) * Transported to Cardiac Catheterization Laboratory

CASE STUDY – 20 YEAR OLD FEMALE * History and Physical * Leg and hip pain 1 day prior * Diagnosis of IM 1 month prior * CBC with DIFF * * * WBC RBC Platelets Neutrophils Lymphocytes Monocytes 8. 6 3. 86 179 66 24 10 [4. 8 -10. 8] [4. 00 -5. 40] [145 -400] [40 -74] [15 -47] [0 -12] K/u. L M/u. L K/u. L % % %

CASE STUDY – 20 YEAR OLD FEMALE * Cardiac catheterization * Blockage of left anterior descending artery

CASE STUDY – 20 YEAR OLD FEMALE * Lipid profile * * Cholesterol HDL LDL Triglycerides 134 42 74 90 [< 200] mg/d. L [> 40] mg/d. L [< 130] mg/d. L [< 200] mg/d. L * Homocysteine 5. 6 [< 10. 4] umol/L * Lipoprotein(a) 15 [< 75] mg/d. L * Cardiolipin antibody Positive [Negative]

CASE STUDY – 20 YEAR OLD FEMALE * Mononucleosis test * Positive (strong) * EBV early antigen, Ig. G * Negative * CBC with DIFF * Normal



- Slides: 75